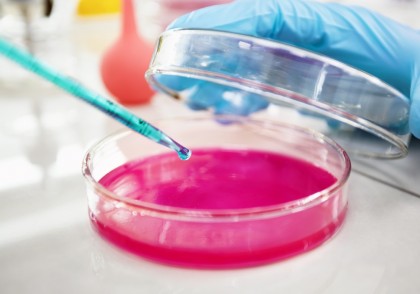
Viermii paraziți și sistemul nervos: cum Schistosoma mansoni „amorțește” pielea pentru a scăpa nedetectat

Viermii paraziți și sistemul nervos: cum Schistosoma mansoni „amorțește” pielea pentru a scăpa nedetectat
Un studiu publicat pe 7 august 2025 în The Journal of Immunology de cercetători de la Tulane School of Medicine a descoperit că parazitul Schistosoma mansoni, responsabil de schistosomiază, reușește să pătrundă în piele fără a provoca durere sau mâncărime printr-un mecanism ingenios: suprimarea neuronilor senzoriali implicați în percepția durerii și a pruritului. Identificarea moleculelor responsabile ar putea deschide drumul către noi tratamente analgezice, alternative la opioide.
Context
Schistosomiaza este una dintre cele mai răspândite boli parazitare, afectând milioane de persoane la nivel global, în special în zonele tropicale și subtropicale. Infecția apare prin contactul cu apă infestată, când larvele pătrund prin piele. În mod obișnuit, pătrunderea unui agent patogen produce inflamație, durere sau prurit, semnale prin care sistemul nervos alertează imunitatea. Totuși, spre deosebire de alți paraziți sau bacterii, larvele de S. mansoni nu provoacă astfel de reacții imediate, ceea ce a intrigat mult timp comunitatea științifică.
Despre studiu
Cercetătorii au analizat interacțiunea dintre S. mansoni și receptorul neuronal TRPV1+, un canal ionic prezent pe neuronii senzoriali implicați în transmiterea senzațiilor de căldură, durere și prurit. Acești neuroni joacă un rol important nu doar în percepția senzorială, ci și în reglarea răspunsului imun, fiind implicați în recrutarea celulelor precum limfocitele γδ T, monocitele și neutrofilele.
Experimentele realizate pe șoareci infectați cu S. mansoni au arătat că parazitul secretă molecule capabile să blocheze activarea TRPV1+, reducând semnalele transmise către creier și, implicit, reacțiile inflamatorii inițiale. Această strategie permite larvelor să pătrundă în organism nedetectate, crescând șansele de supraviețuire și infecție.
Rezultate
-
S. mansoni a redus activitatea neuronilor TRPV1+, blocând senzațiile de durere și prurit.
-
Inhibarea TRPV1+ a dus la o mobilizare redusă a celulelor imunitare în piele, facilitând pătrunderea parazitului.
-
Moleculele secretate de parazit ar putea fi exploatate terapeutic ca analgezice inovatoare, cu potențial de a înlocui opioidele în tratamentul durerii cronice.
-
În același timp, activarea controlată a TRPV1+ ar putea sta la baza unor strategii preventive împotriva schistosomiazei, de exemplu prin creme sau agenți topici care să declanșeze reacții inflamatorii protectoare la contactul cu apa contaminată.
Concluzii și implicații
Descoperirea arată cum paraziții au evoluat mecanisme sofisticate pentru a evita sistemul imun, folosindu-se de „întreruperea” căilor neuronale ale durerii și pruritului. Din perspectivă medicală, aceste molecule parazitare reprezintă o dublă oportunitate:
-
pot inspira dezvoltarea unor noi medicamente analgezice, mai sigure decât opioidele;
-
pot contribui la elaborarea unor tratamente profilactice împotriva infecțiilor parazitare.
Studiul subliniază importanța conexiunilor dintre sistemul nervos și cel imunitar, arătând că neuronii senzoriali nu sunt doar detectoare ale mediului extern, ci și actori esențiali ai imunității cutanate.
Sursă imagine: https://www.freepik.com/free-photo/hands-clinician-holding-tools-scientific-experiment-laboratory_10271333.htm
Copyright ROmedic: Articolul se află sub protecția drepturilor de autor. Reproducerea, chiar și parțială, este interzisă!
- Infuzide, un nou compus cu activitate antimicrobiană promițătoare împotriva stafilococilor și enterococilor multirezistenți
- Creșterea infecțiilor cu virusul Toscana în Italia evidențiază riscurile pentru sănătate determinate de climă
- Virusul gripal manipulează sistemul de reglare genetică a organismului pentru a-și accelera propria răspândire
- Vitamina D protejează împotriva infecției cu H1N1 și SARS-CoV-2 la șoareci
- Pot fi paraziti intestinali?
- Paraziti intestinali au vreo legatura cu respiratia urat mirositoare?
- Paraziti intestinli
- Oxiuri - nu stiu ce sa mananc, ca am inteles ca nu am voie carne sucuri lapte branza dulciuri
- NIKVORM
- Paraziti intestinali copil
- Tratament pentru toti parazitii din corp